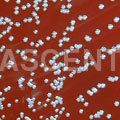
Mineral Chemical Supplements

Bacterial Mixture Identification
Price:
Get Latest Price
In Stock
Product Specifications
| Solutions | Multiple types |
| Packaging | Flasks |
| Volumes | 250ml, 1L |
| Staining | Gram, etc |
| Purity | High grade |
| Storage | Room temp |
| Shelf Life | Variable |
| Features | Accurate identification, Fast results, Reliable analysis, Easy to use, Cost-effective, Versatile solutions |
Company Details
Welcome to Our !Company Profile Associated Scientific Enterprises was established in the epochal year of 1977. We are manufacturers, exporters and suppliers of quality electromedical and OT equipments. We have been successful in establishing our bases in the countries like Kenya, Iraq, Sri Lanka, Bangladesh, Nepal, Uganda, South Africa, Asian Countries and Middle East. We are an ISO 9001:2000 certified company. Our primary competitive advantage lies in perfection and efficiency of each medical equipments produced by us. The wider reach of our products in the national as well as In
Business Type
Manufacturer, Supplier, Trading Company
Employee Count
35
Establishment
1977
Working Days
Monday To Sunday
Related Products
More Product From This seller
Seller Details
Delhi, Delhi
Partner
Mr. Ankit Gupta
Address
Plot No. 5324-25, Basti Harphool Singh, Sadar Thana Road, Delhi, Delhi, 110006, India
Lab Chemicals & Supplies in Delhi
Report incorrect details